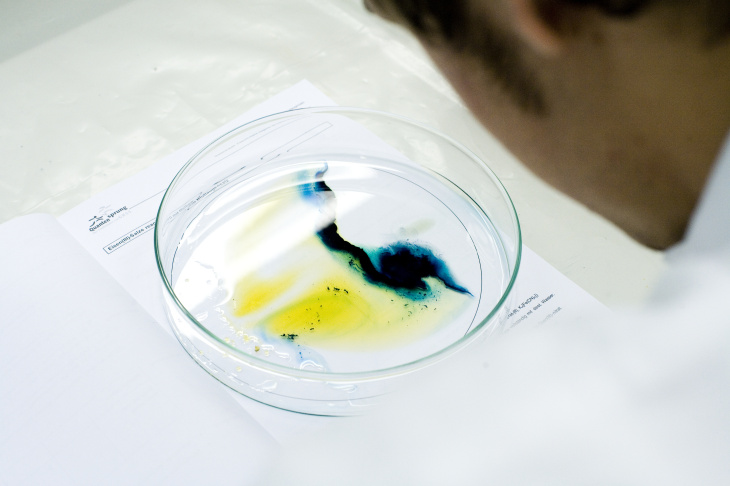

Aktuelles
Experimentiertage in den Sommerferien

Foto. Hereon/Mendach
Für Kinder von 7 bis 14 Jahren
Erlebe Wissenschaft hautnah!
Im Schülerlabor Quantensprung am Helmholtz-Zentrum Hereon erwarten dich spannende Experimente, lustige Spiele und faszinierende Forschung. Wie echte Wissenschaftler*innen arbeitest du mit professionellen Laborgeräten und entdeckst die Welt der Naturwissenschaften auf spielerische Weise.
Die Experimentiertage finden in Kooperation mit den regionalen Orts -und Stadtjugendringen (OJR und SJR) statt. Die Anmeldungen bitte direkt dort.
Termine & Anmeldung:
Werkstoffferien 2025 am Hereon

Der Werkstoffwissenschafler Lucas Salomao de Oliveira bereitet gemeinsam mit den Schülern an der Reibauftragschweißmaschine bei WDS eine Aluminium-Mehrschicht-Reibauftragschweißung vor. Foto: Hereon/Arne Roos
Die Werkstoffferien finden im Auftrag des Bundesministeriums für Bildung und Forschung (BMBF) in den Herbstferien statt und richten sich bundesweit an Jugendliche, die Spaß an naturwissenschaftlichen Fragestellungen haben. Ziel der Maßnahme ist es, das Interesse für die Materialwissenschaft und Werkstofftechnik als fächerübergreifende Querschnittstechnologien für den späteren beruflichen Ausbildungsweg zu wecken und eine Möglichkeit zu schaffen, sich intensiv mit diesen faszinierenden Themen zu beschäftigen. Die Teilnehmer*innen werden für eine Woche an eine der beteiligten Forschungseinrichtungen eingeladen. Die Werkstoffferien am Hereon finden vom 13. bis 17. Oktober 2025 statt. Das Schülerlabor bietet gemeinsam mit mehreren Wissenschaftlerinnen und Wissenschaftlern ein abwechslungsreiches und institutsübergreifendes Programm für vier interessierte Jugendliche ab16 Jahren an. Weitere Informationen zu den Werkstoffferien
Ansprechpartner und Anmeldungen unter:
VDI Technologiezentrum GmbH
Schülerlabor Quantensprung engagiert sich im Enrichment-Programm

Bei dem Kursteil Werkstoffforschung durfte jeder sein selbstgemachtes „Schmuckstück“ mitnehmen. Foto: Hereon/Cirotzki
Das Schülerlabor Quantensprung hat sich im Schuljahr 2024/25 erstmalig mit zwei Nachmittagsangeboten im Enrichment-Programm engagiert. Das Programm bietet talentierten Schülerinnen und Schülern die Möglichkeit, in außerschulischen Kursen in kleinen Gruppen mit ähnlich Begabten anderer Schulen auf einem höheren Niveau zu lernen. Die Teilnehmenden werden von ihren Schulen nominiert und bringen ähnliche Interessen sowie Denk- und Arbeitsweisen mit, um sich weiterzuentwickeln. Insgesamt 24 Schülerinnen und Schüler der Klassen 7 bis 10 erhielten die Gelegenheit, einmal wöchentlich als Junior-Forscher am Hereon zu agieren. An 20 Nachmittagen forschten sie in verschiedenen Experimentier-Workshops zu den Themen Erneuerbare Energien, Bionik, Flammschutz sowie Polymere- und Metallforschung.
Das Angebot ist so gut angekommen, dass wir auch im nächsten Schuljahr 25/26 wieder beim Enrichment-Programm mitmachen.
Quantensprung lädt zu zwei spannenden Experimentalworkshops ein

Experimente mit einer Brennstoffzelle. Foto: Hereon/Schmidt
Im Rahmen der Veranstaltungsreihe "Forschung erleben" bietet das Schülerlabor Quantensprung vom Helmholtz-Zentrum Hereon in diesem Jahr zwei faszinierende Workshops für experimentierfreudige Laien an.
Faszination Wasserstoff - Experimentalworkshop für interessierte Laien
Wasserstoff gilt als zentraler Baustein der Energiewende. Das Schülerlabor Quantensprung veranstaltet einen Workshop zum Thema Wasserstoff und Wasserstofftechnologie für experimentierfreudige Laien. Die Teilnehmer haben die Möglichkeit, experimentell mehr über die Gewinnung und Speicherung von Wasserstoff sowie seine Verwendung in der Stromproduktion zu erfahren. Dieser Workshop bietet eine einzigartige Gelegenheit, die Forschung in diesem Bereich hautnah zu erleben und findet am 24.03.25 von 17:30 bis 19:00 Uhr statt.
Einblick in die Nanotechnologie – Experimentierworkshop für interessierte Laien
In den letzten Jahrzehnten hat sich aus Physik, Chemie, Biologie, Medizin und Materialwissenschaften die interdisziplinäre Wissenschaft der Nanotechnologie entwickelt. Das Schülerlabor Quantensprung veranstaltet einen Workshop zum Thema Nanotechnologie für experimentierfreudige Laien. Die Teilnehmer haben die Möglichkeit, experimentell einige interessante Nanoprodukte, wie Ferrofluid und Formgedächtnismaterialien, kennenzulernen und mehr über ihre faszinierenden Eigenschaften und Anwendungen zu erfahren. Der Workshop findet am 17.06.25 von 17:30 bis 19:00 Uhr statt.
Anmeldung und Teilnahme
Die Teilnahme an beiden Workshops ist kostenlos, jedoch ist eine Anmeldung erforderlich. Interessierte können sich telefonisch bei der VHS-Geesthacht oder online anmelden.
zur Anmeldung
Osterspezial-Workshop: Eier-Entdecker - Spannende Experimente rund ums Ei

Foto: Hereon/Grohn
In unserem Osterspezial-Workshop für Grundschulkinder dreht sich alles um das Thema Hühnerei! Die Kinder werden in unserem Schülerlabor Quantensprung verschiedene spannende Experimente durchführen, die ihnen die Eigenschaften und den Aufbau von Eiern näherbringen.
Der Workshop findet am 15. April 2025 von 09:30 Uhr bis ca. 12:00 Uhr statt. Eine Anmeldung unter quantensprung@hereon.de ist unbedingt erforderlich, da die Plätze begrenzt sind und die Nachfrage erfahrungsgemäß groß ist. Bei der Anmeldung bitte Name und Alter des Kindes angeben. Jedes Kind muss 3 frische, saubere, rohe Eier und drei gekochte Eier zum Experimentieren mitbringen.
Wir freuen uns auf einen bunten Workshop voller Entdeckungen und Spaß mit Ihren Kindern!
Ferienwochenkurse in den Sommer- und Herbstferien ausgebucht!

Der Kurs in den Sommerferien war innerhalb kurzer Zeit ausgebucht! Aufgrund der großartigen Resonanz veranstalten wir diese Entdeckerwoche nochmal in den Herbstferien. Sie findet in der Zeit vom 21.10.24 bis zum 25.10.24 jeweils von 9:00 Uhr bis 13:00 Uhr statt. Auch dieser Kurs ist bereits ausgebucht!
„Rätsel, Wunder, Phänomene! Entdeckerwoche im Schülerlabor Quantensprung
In der Ferienwoche vom 22.07.24 bis 26.07.24 jeweils von 9:00 Uhr bis 13:00 Uhr laden wir alle interessierten Grundschulkinder ein, gemeinsam mit uns den naturwissenschaftlichen Geheimnissen auf den Grund zu gehen Wir werden geheimnisvolle Rätsel lösen und verblüffende Experimente durchführen. Höhepunkt wird eine Quizshow am Freitag sein, bei der die jungen Forscherinnen und Forscher ihr Wissen unter Beweis und ihre Eltern und Gäste auf die Probe stellen können. Lasst euch diese Chance nicht entgehen, meldet euch an und seid dabei, wenn wir gemeinsam auf rätselhafte Entdeckungsreise gehen!
Die Plätze sind begrenzt und eine Anmeldung ist unbedingt erforderlich!
Anmeldungen und weitere Informationen unter sabine.mendach@hereon.de.
Elektrisierendes Experimentieren in den Osterferien im Schülerlabor
Das Team vom Schülerlabor Quantensprung vom Helmholtz-Zentrum Hereon lädt alle Kinder im Grundschulalter zu einer Experimentierreise in den Osterferien ein. Gemeinsam wollen wir spannende Rätsel rund um den Strom lösen, indem wir viele interessante und „elektrisierende“ Versuche durchführen. Was knistert in der Luft? Wie kann man mit dem Luftballon eine Lampe zum Leuchten bringen? Strom aus einer Kartoffel-wie geht das?
Das Experimentierangebot findet am 16. April 2024 um 09:30 Uhr bis ca. 12:00 Uhr im Schülerlabor statt. Eine Anmeldung unter quantensprung@hereon.de ist unbedingt erforderlich, da die Plätze begrenzt sind und die Nachfrage erfahrungsgemäß groß ist. Bei der Anmeldung bitte Name und Alter des Kindes angeben.
Bei Fragen zur Experimentierreise wenden Sie sich gern an sabine.mendach@hereon.de.
Quantensprung Schülerlabor fördert MINT-Kompetenzen bei Grundschülern
Die Corona-Pandemie hat in vielen Bereichen Spuren hinterlassen, insbesondere bei den Kindern im Grundschulalter, die stark von den Einschränkungen betroffen waren und bis heute mit Lernrückständen zu kämpfen haben. Um diesem Problem entgegenzuwirken, hat das Team Quantensprung in diesem Jahr ein besonderes Angebot für regionale Grundschulen ins Leben gerufen.
Bereits über 250 Schülerinnen und Schüler der 4. Klasse haben in diesem Jahr die Möglichkeit genutzt, einen Tag lang in unseren Laboren zu experimentieren. Dieses Angebot zielt darauf ab, die MINT-Kompetenzen der Kinder zu fördern, was in Grundschulen oft schwer umzusetzen ist. Aus diesem Grund haben alle regionalen Grundschulen von diesem Angebot Gebrauch gemacht.
Das Team Quantensprung freut sich über die Begeisterung und Neugierde, mit der die Kinder bei den Experimenten dabei waren. Außerdem war es eine willkommene Abwechslung für das Team, da die Angebote des Schülerlabors normalerweise für Klassen ab Jahrgang 10 konzipiert sind.
„ZUKUNFT GESTALTEN“ mit dem Schülerlabor
Am 8. März 2024 fand die MINT-Tagung Hamburg 2024 am Landesinstitut für Lehrerbildung und Schulentwicklung in Kooperation mit dem MNU-Hamburg statt. Das Schülerlabor Quantensprung unterstützte die Veranstaltung und organisierte einen Experimentierworkshop zum diesjährigen Thema "Zukunft gestalten". Über 250 Lehrkräfte nahmen an der Tagung teil und hatten die Möglichkeit, innovative Ideen und Methoden auszutauschen. Der Info-Stand des Schülerlabors präsentierte vielfältige Exponate und lud die Teilnehmer zur Interaktion ein. Die Tagung bot somit eine Plattform für den gemeinsamen Austausch und die Weiterentwicklung im MINT-Bereich.
Mitmach-Stand beim „Mint Festival Kultur*en“

Energieerzeugung durch Muskelkraft mithilfe des Ökotrainers (Foto: Hereon/Dr. Anna-Lena Giertz)
Am 17. November 2023 war unser Schülerlabor in Bad Oldesloe bei den „Mint Festival Kultur*en“ zu Gast. Dieses Event wurde von der Agentur für Arbeit Bad Oldesloe, der Beruflichen Schule Bad Oldesloe sowie der Europa Universität Flensburg und der Phänomenta organisiert.
Das Ziel der MINT Veranstaltung war es, Schülerinnen und Schüler über einen niedrigschwelligen Kontakt für MINT zu begeistern. Für die Workshops und Ausstellungsstände wurden verschiedenste Unternehmen und Institutionen eingeladen, um ihre Ausbildungsberufe und Studiengänge im Bereich MINT vorzustellen, auch wir, dass Schülerlabor Quantensprung wurden eingeladen um unser Forschungszentrum sowie das Thema „Mit Wasserstoff in die Zukunft fahren“ vorzustellen.
Der Ausstellungsstand war gut besucht. Vor allem die Jugendlichen und jungen Erwachsenen waren sehr von dem Ökotrainer, unser Exponat mit dem es möglich ist, Muskelkraft in Energie umzuwandeln, begeistert. Auch die Lehrkräfte fühlten sich von unserem Ausstellungsstand sehr angesprochen und informierten sich über unsere Angebote. Wir sind erfreut einige von Ihnen bald in unserem Schülerlabor wiederzusehen.
Quantensprung begeistert

Gebannte Teilnehmende beim Quantensprung-Workshop während der Bundeskonferenz 2016 in Hamburg (Foto: MIT Club of Germany e.V.)
„Begeisterer begeistern“ — unter diesem Motto veranstaltete der MIT Club of Germany e.V. die Konferenz Schule MIT Wissenschaft für Lehrende in den MINT-Fächern. Mit dabei auch unser Schülerlabor Quantensprung.
An der jährlich stattfindenden Veranstaltung nehmen jeweils rund 100 Lehrkräfte aus dem ganzen Bundesgebiet teil. Die Konferenz findet jedes Jahr in einem anderen Bundesland statt, so dass sukzessiv Wissensstädte im gesamten Bundesgebiet als Austragungsort erreicht werden. Dieses Jahr fand die Bundeskonferenz Schule MIT Wissenschaft 2023 vom 10. bis 12. November in Kiel statt. Zum zweiten Mal war auch das Schülerlabor dabei, das vorige Mal 2016 in Hamburg.
Das Schülerlabor Quantensprung veranstaltete zwei Experimentier-Workshops. Ihre Kernfrage war, ob der Ingenieur Cyrus Smith auf der Nautilus mit dem Satz richtig lag, als Autor Jules Verne ihn sagen ließ, “Ich glaube, dass Wasser eines Tages als Brennstoff dienen wird.“ Heute wissen wir, dass Wasser kein Brennstoff ist, aber man daraus den Brennstoff „Wasserstoff“ erzeugen kann. Eine Problematik der erneuerbaren Energien wie Wind- und Solarenergien ist ihre nicht ständige Verfügbarkeit.
Im Workshop „Erneuerbare Energien praktisch erfahren – Wasserstoff- und Brennstoffzelle“ wurde Wasserstoff als mögliches Speichermedium vorgestellt. In unterschiedlichen Experimenten konnten die über 30 Lehrkräfte aus ganz Deutschland Wasserstoff und Sauerstoff aus Wasser per Elektrolyse mit Solarenergie gewinnen, messen und nachweisen. Mit dem Einsatz der Brennstoffzelle war es ihnen selbst möglich eine Umwandlungskette von der Erzeugung und Speicherung des Wasserstoffs bis zur Umsetzung in elektrische Energie aufbauen. Außerdem wurde die neueste Forschung im Bereich Metallhydride und Wasserstoffspeicherung vom Hereon vorgestellt.
MINT-Festival in Trittau

Knallgasprobe [Foto: Hereon/Franziska Grohn]
Zum zweiten Mal lud das Ministerium für Allgemeine und Berufliche Bildung, Wissenschaft, Forschung und Kultur des Landes Schleswig-Holstein zu einem landesweiten MINT-Festival ein. Das Motto des MINT-Festivals 2023 hieß „Mit innovativen Ideen zur Klimaneutralität!“ und Gastgeber war dieses Jahr das Gymnasium Trittau.
Bewerben konnten sich, unabhängig von der Schulart, alle Schülerinnen und Schüler ab der Jahrgangstufe 7. Dabei waren alle Themenbereiche und fachlichen Schwerpunkte erwünscht und willkommen. Die fachkundige Jury hat Mitte Juni entschieden, welche Teams oder Einzelpersonen mit ihren Projekten eines der 100 Tickets für das Festival erhalten.
Das Festival begann am Freitag, 22.09.23 mit einer feierlichen Eröffnung durch Staatssekretärin Dr. Dorit Stenke und spannenden Vorträgen verschiedener Forschenden.
Am Samstag wurden die Teilnehmerprojekte vorgestellt, welche teilweise schon Preise bei Jugend forscht gewannen oder auch Patentanmeldungen erhielten. Sie fanden ein großes Interesse bei den anderen Teilnehmenden sowie auch der interessierten Schulöffentlichkeit von Schülerinnen und Schülern und auch Eltern.
Am Sonntag fand eine Workshop-Session statt, bei der auch wir, das Schülerlabor des Hereons, zwei Workshops mit dem Titel „Ist Wasserstoff der/ein Energieträger der Zukunft?“ veranstalteten. Mit fast 30 Teilnehmenden haben wir experimentell die Gewinnung, die Nutzung und die Speicherung von Wasserstoff untersucht und zusammen mit aktuellen Forschungsergebnissen aus dem Hereon betrachtet. Eine insgesamt gelungene Veranstaltung.
Magie der Chemie - Ferienprogramm im Quantensprung

Foto: Fotolia/Lev Dolgachov
Spannende und erlebnisreiche Experimentiertage bot das Schülerlabor Quantensprung in diesen Sommerferien für Kinder im Alter von 7 bis 14 Jahren an.
An zwei Terminen im Juli erlebten die Jungforschenden, natürlich mit Laborkittel und Schutzbrille ausgestattet, fliegende Raketen, eine Rotkohlorgel, eine Lavalampe und noch vieles mehr! Die Kinder konnten zudem mit echten Laborgeräten experimentieren und dabei die Magie der Chemie kennenlernen.
YES! MINT Finale 2022 in Kiel
![Das Schulteam vom Gymnasium Kronwerk. [Foto:YES! – Young Economic Solutions]
Das Schulteam vom Gymnasium Kronwerk.](/imperia/md/assets/quantensprung/fittosize_730_0_6282630c9e5e49d445f25bb5b4bb8ea2_schulerlabor_mint_2022_siegerfoto.jpg)
Das Schulteam vom Gymnasium Kronwerk. [Foto:YES! – Young Economic Solutions]
Mit Spannung haben wir das YES! MINT Finale 2022 erwartet. Neben Teams aus ganz Schleswig-Holstein qualifizierten sich auch die Schüler:innen vom Gymnasium Kronwerk für das Finale am 16. Dezember in der ZBW in Kiel. Dabei durften wir vom Schülerlabor Quantenschsprung in Zusammenarbeit mit Prof. Dr. Julian Jepsen seit Anfang November das Team bei der Fragestellung „Welche Rolle wird Wasserstoff in der Energieversorgung der Zukunft spielen?“ unterstützen.
Unter dem Slogan: „Gas geben… aber ricHtig!“ präsentierten die Rendsburger Schüler:innen ihre Visionen und Lösungsansätze und konnten sich am Ende eines spannenden Finaltages den 2. Platz sichern. Wir freuen uns sehr und gratulieren ganz herzlich zu diesem tollen Erfolg!
Zusammen mit den Erst- und Drittplatzierten Teams dürfen sich die Rendsburger:innen zusätzlich über die Teilnahme an einem der MINTKultur*en Festivals 2023 freuen, bei dem sie ihre Ideen, Lösungsansätze und Visionen noch einmal vor großem Publikum vorstellen dürfen.
Kurzbericht zum Finale
Presseinformation

YES! MINT – Finale 2022 in der ZBW in Kiel. [Foto: YES! – Young Economic Solutions]
YES! MINT im Schülerlabor

Die Schüler:innen lauschen gespannt dem Vortrag von Prof. Dr. Julian Jepsen über Wasserstofftechnologie. [Foto: Natalya Grohn/Hereon]
Am 1. November waren 30 Schüler:innen der 8. und 9. Klassenstufe des Gymnasium Kronwerk aus Rendsburg im Rahmen des Schulwettbewerbs YES! MINT zu Gast im Schülerlabor.
Als Schulwettbewerb ist YES! MINT an der herausfordernden Schnittstelle zwischen Wirtschaft und MINT-Fächern angesiedelt. Im Rahmen des Wettbewerbs sollen Schüler:innen der Klassenstufen 7-9 gemeinsam mit Forschenden aus renommierten Forschungsinstituten eine eigene Problemanalyse und Vision zu regionalen und globalen Herausforderungen, angelehnt an den 17 Zielen für nachhaltige Entwicklung der Vereinten Nationen, entwickeln.
Im Schülerlabor bekamen die Schüler:innen von Prof. Dr. Julian Jepsen einen hochinteressanten Einblick in den aktuellen Stand der Wasserstoffforschung, um sich im Anschluss mit Experimenten zur Fragestellung, „Welche Rolle wird Wasserstoff in der Energieversorgung der Zukunft spielen?“, einen eigenen Einblick in die Möglichkeiten der Wasserstofftechnologie zu verschaffen.
Beim Wettbewerbsfinale im Dezember werden die Schulteams dann ihre ausgearbeiteten Problemanalysen und Visionen zu den gewählten Themen vorstellen und diskutieren. Zusammen mit einer Jury wird dann über das beste Schulteam entschieden.
Mal schauen ob Wasserstoff Chancen auf eine vordere Platzierung hat…
Schülerlabor engagiert sich für ukrainische Kinder

Rotkohlorgel. Mit Pottasche, Natron, Zitronensaft, Milch, Seife, Backpulver und dem Rotkohlsaft wird eine Farborgel in den Reagenzgläsern erstellt. Foto: Franziska Grohn/Hereon
Der Krieg in der Ukraine dauert nun schon mehrere Monate an und immer mehr geflüchtete Menschen suchen auch bei uns in Norddeutschland Schutz, darunter auch viele Kinder. Diesen ukrainischen Kindern weiterhin eine umfassende Bildungsmöglichkeit zu gewährleisten, stellt für viele Schulen eine Herausforderung dar. Deshalb hat das Schülerlabor „Quantensprung“ ein speziell an diese Kinder angepasstes Programm zur Sprachförderung entworfen.
Im Mai stellten sich zusammen mit dem Forscherraben Quanti mehr als 130 Kinder spannenden Rätseln und versuchten diese mit vielen Experimenten zu lösen. Dann hieß es nicht mehr nur „Was sprudelt in der Brause?“ und „Wie hoch fliegt eine Plastikdose?“, sondern auch „що булькає в газировці?“, „як високо може літати пластиковий стакан?“
Unsere Kollegin Natalya Grohn ist gebürtige Ukrainerin und ausgebildete Lehrerin und brachte daher die perfekten Voraussetzungen mit, ukrainischen Kindern durch die Experimentiertage zu begleiten. Und natürlich war es für sie auch eine Herzensangelegenheit Menschen aus ihrem Heimatland bei der Integration in Deutschland zu unterstützen.
Ganz besonders freute sich das Schülerlabor über die Resonanz zu dem Angebot. Die Nachfrage war so groß, dass die Kurse auch für geflüchtete Kinder aus anderen Staaten und für DAZ-Klassen (Deutsch als Zweitsprache) durchgeführt wurden und Kinder aus 11 verschiedenen Nationen erfolgreich teilnehmen konnten.
Das Feedback der Lehrkräfte stellte dar, dass neben den inhaltlichen Erkenntnissen, das gemeinsame Erlebnis dazu beigetragen hat, dass Lehrkräfte und Kinder sich noch besser kennengelernt haben.
Berufsbilder in der Forschung-kurz erklärt

Bild: Schülerlabore der Helmholtz-Zentren
Den Nerv der Zeit getroffen hat das Schülerlabor „Quantensprung“ am 03.03.2022 mit der Ausrichtung einer digitalen Veranstaltung zur Berufsorientierung für interessierte Schüler*Innen aus ganz Deutschland.
In Zusammenarbeit mit den Schülerlaboren des Alfred-Wegener-Instituts (AWI) und des Geomar wurde ein neues, zentrumübergreifendes Konzept entwickelt und ein breites Spektrum an Berufsgruppen aus Forschung und Wissenschaft aufgestellt.
Neben einer Geowissenschaftlerin, einer Klimamodelliererin und einer Chemikerin (Hereon) haben unter anderem auch eine Biologielaborantin, eine Schiffsbauingenieurin (Hereon), eine chemisch-technische Assistentin und zwei FSJlerinnen ihre spannenden Berufsfelder vorgestellt. Bereits die Bewerbung stieß auf großen Anklang und viele positive Rückmeldungen, sodass schlussendlich 71 Teilnehmer*Innen, davon 70% Mädchen, den informativen Kurzvorträgen der Referentinnen folgten.
Anschließend hatten alle Teilnehmer*Innen die Möglichkeit in einem offenen Gespräch in Kleingruppen ihre Fragen persönlich den Wissenschaftlerinnen zu stellen. Es wurden so viele interessante Fragen gestellt, dass die Zeit von 15 Minuten pro Gruppe teilweise nicht ausreichte. Das zeigt wie begeistert beide Seiten bei dieser Veranstaltung dabei waren. Nicht nur den Referentinnen habe es Spaß gemacht ihre Erfahrungen weiterzugeben, sondern auch für viele Schüler*Innen sei es sehr hilfreich zur Orientierung gewesen.
Zunächst skeptisch aufgenommen und am Ende sehr gelobt wurde auch die Entscheidung, ausschließlich Frauen als Vortragende einzuladen. „Ich hatte mich zunächst darüber gewundert, dann aber kamen einige Fragen zu Möglichkeiten der Familienplanung in der Wissenschaft während der Fragerunde. Dies scheint für Schülerinnen tatsächlich eine Rolle bei der Berufswahl zu spielen“, stellt eine Referentin fest.
Dennoch werden diese und ähnliche Themen/Fragen nur unzureichend angesprochen, dabei sind Frauen bis heute in der Forschung unterrepräsentiert. Umso wichtiger ist es also, zu zeigen, dass auch sie in der Wissenschaft erfolgreich sein können. Den Ausrichtern ist es definitiv gelungen, die Forschung von einer etwas anderen Seite zu beleuchten und den ambitionierten Schülerinnen einen Raum für ihre Fragen zu bieten.
Der Dank geht nochmal ganz besonders an Frau Dr. Sabine Mendach für die Idee des Konzeptes, Herrn Dr. Joachim Dengg und Frau Dr. Antje Wichels für die Unterstützung bei der Organisation und an alle Referentinnen für Ihr Engagement!
E-Mail an: schulprogramme@geomar.de
Online-Experimentierveranstaltung „Chemie auf der Haarspitze“

©Foto Hereon / Zinkevych
Wie dick ist ein Haar? Gibt es Dinge, die noch kleiner sind, und wie können wir sie erkennen? Was ist ein Nanometer, und was ist daran so besonders, nur ein Nanometer groß zu sein?
Alle Kinder, die Spaß am Experimentieren haben und in die 4. – 7. Klasse gehen, sind herzlich zur Online-Veranstaltung eingeladen.
Das Schülerlabor „Quantensprung“ hat für euch spannende Experimente vorbereitet: einen Trick mit der Seifenblase; ein merkwürdiges Gemisch, das mal flüssig und mal fest ist; wie eine Mütze zum Helm wird; Lotusblätter unter der Lupe und vieles mehr.
Diese Veranstaltung findet über Zoom am Samstag, 26.02.2022 um 10:00 Uhr und am 01.03.2022 um 16:00 Uhr statt. Die Zugangsdaten und weitere Experimentierunterlagen erhaltet ihr nach der Anmeldung.
Sichert euch einen der begehrten Plätze und meldet euch bis um 17.02.2022 mit Wunschtermin via E-Mail an.
Wir freuen uns auf euch!
E-Mail an das Schülerlabor Quantensprung
Online-Experimente „Dem Klima auf der Spur“

Moritz bestaunt die Wolke im Wasserglas
©Foto Hereon/Birte Cirotzki
Warum wird es immer wärmer auf der Erde, aber nicht überall gleich stark? Wodurch kommt es zu Überschwemmungen - nur durch Eisschmelze? Du möchtest dem Klima auf die Spur kommen, dabei Spaß haben und bist in der 4.- 6. Klasse? Das Schülerlabor „Quantensprung“ führt mit dir Experimente wie Überschwemmungen, Regen, Wolken und Sturm im Wasserglas durch. Auch der Treibhaus- und Albedo-Effekt werden simuliert. Du weißt nicht, was das ist, möchtest es aber herausfinden? Dann besuche uns online per Zoom am 15.2.22 um 16:00 Uhr. Die Zugangsdaten sowie Experimentierunterlagen erhältst du nach Anmeldung. Sichere dir schnell einen der begehrten Plätze und melde dich bis zum 30.01.22 via E-Mail an.
Wir freuen uns auf dich!
E-Mail an das Schülerlabor Quantensprung

Foto: Titelfolie des Weihnachtsmärchens
Schneeflocken rieselten vom Himmel, die Kerzen auf dem Adventskranz brannten und im Hintergrund spielte leise die Weihnachtsmusik. Es war Weihnachten geworden im Schülerlabor Quantensprung.
Am 04. und 20. Dezember 2021 lauschten insgesamt 50 Kinder im Alter von 5-12 Jahren gespannt unserer FSJlerin Lea Kimpel als sie die Geschichte vom kleinen Weihnachtswichtel vorgelesen hat. Der Wichtel musste einige Probleme auf seiner Suche nach dem Weihnachtsfest bewältigen, bei denen ihn die Kinder tatkräftig mithilfe vieler Experimente unterstützten.
Neben Eis, das selbst hergestellt wurde, wurden auch ein Rückstoßauto und eine Lava-Lampe selbst gebastelt (s. Foto-Reihe).
Aufgrund der wieder verschärften Corona-Lage konnte diese Experimentierreise nicht wie geplant vor Ort in unserem Labor stattfinden, sondern nur online über Zoom, was zunächst zu Skepsis bei einigen Teilnehmenden geführt hatte. Am Ende waren aber alle positiv überrascht und hatten sehr viel Spaß, besonders beim Eis essen und Fahren des Autos.
Uns vom Schülerlabor hat es sehr gefreut, dass wir durch die Onlineveranstaltung nicht nur Kinder aus Geesthacht und Umgebung, sondern auch aus Berlin, Baden-Württemberg und Bayern willkommen heißen konnten.
Für alle war es sicherlich eine willkommene Abwechslung in einer doch schwierigen Zeit!
Wie kann man ein Glas hochheben, ohne es mit der Hand anzufassen? Wie viele Tropfen Wasser passen auf eine Münze? Und wie kann man Wasser stapeln?
Das waren einige der kniffligen Fragen, denen sich am 02. Oktober 16 Hereon-Kinder im Alter von 5-12 Jahren im Schülerlabor gestellt haben. Denn nach langer, langer Corona-Pause durften wir nun auch endlich unsere Jüngsten wieder vor Ort im Labor empfangen.
Ganz nach dem Motto „1, 2 oder 3“ wurde in den zwei Stunden zunächst geraten, welcher der jeweils drei Gegenstände der richtige für die Aufgabe sei. Danach wurde in vielen verschiedenen Experimenten nach der Lösung gesucht. Durch das Quiz geführt wurden die Kinder von der “Wissenschaftlerin“ Sabine Mendach und ihrem Hilfsraben Quanti.
Auch wenn es bei den Quizfragen nicht immer so war, waren sich alle doch bei einer Sache einig. Es hat viel Spaß gemacht und alle freuen sich schon auf den nächsten Experimentiertag im Schülerlabor.
In diesen Sommerferien (2021) veranstaltete das Schülerlabor eine kleine digitale Entdeckerreise. Dabei wurde die heimische Küche zum Chemielabor und die Kinder zu Eisforschern. Es wurden salziges und süßes Eis untersucht und andere spannende Sachen wie den Lotus-Effekt entdeckt. 40 Kinder im Alter von 7 bis 12 Jahren nahmen an 5 Terminen an dem Online-Angebot teil. Jedes Kind bekam im Vorwege ein Experimentierpacket nach Hause geschickt, damit war die Vorfreude besonders groß und alle mit Begeisterung dabei. Besonderes Highlight war das selbstgemachte Slush-Eis, welches am Ende sogar vernascht werden konnte.
Es ist nicht mehr lange hin bis Ostern. Wir möchten euch ein Experiment präsentieren, das hoffentlich für gute Laune sorgt und einfach Zuhause nachzumachen ist. Eine Experimentieranleitung ist natürlich auch mit dabei. Viel Spaß beim Zuschauen und Experimentieren! Frohe Ostern und erholsame Feiertage wünscht das Schülerlabor „Quantensprung“ Experimentieranleitung für die "Handschuhpflanzen" (330 KB)
Der Film zum Experiment:
Ob Schulferien oder vorübergehende Schulschließungen – in diesen Zeiten sind sinnvolle und originelle Ergänzungen zum digitalen oder hybriden Lernen wichtig. Die dritte Ausgabe der Broschüre „Experimente für zuhause“ zeigt Kindern, Jugendlichen und ihren Eltern, wie sie ihr Zuhause kurzerhand zum Forschungslabor machen können, und gibt Lehrkräften Inspirationen, um den Schulalltag mit spannenden Experimenten aufzuwerten. Die Broschüre mit verschiedenen Versuchen wurde vom Schülerlabor Quantensprung in Zusammenarbeit mit dem Netzwerk der Schülerlabore erstellt und steht als Download bereit.
Weitere Anregungen zum Forschen und Experimentieren für große und kleine Forscher*innen befinden sich auf der Website der Helmholtz Schülerlabore.
Der intelligente Weihnachtsbaum
Auf dem Video ist eines der Experimente aus dem Kurs "Einblick in die Nanotechnologie" zu sehen, das hier weihnachtlich gestaltet wurde. Details zum Versuch sind unten im Anhang zusammengefasst. Versuchsinformationen (581 KB)
Schülerlabor mobil
Wasseranalytik, Foto: Hereon
Mitte November hätte das Schülerlabor die 11. Klasse der Ida-Ehre-Schule während ihrer Vorhabenwoche zu Besuch gehabt. Die Klasse durfte wegen Corona leider nicht ins Schülerlabor kommen.
Damit die Vorhabenwoche aber doch stattfinden konnte, konzipierte das Quantensprung-Team die Experimentiertage neu und verschickte das nötige Material, sodass die Lehrkraft sämtliche Experimente mit Hilfe von extra erstellten Informationsmaterial selbstständig vor Ort in der Schule durchführen konnte.
Das "Schülerlabor mobil" war ein voller Erfolg, wie man an der Danksagungsmail sieht:
Danksagung Quantensprung (110 KB)
27. August 2020: Aktueller Stand für das Schuljahr 2020/21
Wir freuen uns, dass wir wieder Praktikumskurse im Schülerlabor Quantensprung anbieten können. Aufgrund der COVID-19-Pandemie mussten wir unser Programm anpassen.
Die angepassten Praktikumskurse finden von 9 Uhr bis 12 Uhr statt, inkl. zweier Pausen (jeweils 10-15 min).
Mögliche Themen:
> "Einblick in die Wasseranalytik" (zurzeit max. 12 Teilnehmer)
> "Erneuerbare Energien-praktisch erfahren" (zurzeit max. 14 Teilnehmer)
Da die Teilnehmerzahl sehr begrenzt ist und für eine Klasse meist nicht ausreicht, bekommen Sie von uns pro Klasse gern mehrere Termine.
Nutzen Sie zur Anmeldung bitte das Anmeldeformular.
Bei Fragen, wenden Sie sich gern per Mail an die Laborleitung.
Lehrerfortbildung am Helmholtztag „Wissenschaftstransfer gelebt“
In kurzen Workshops lernen Sie die verschiedenen Angebote des Schülerlabors „Quantensprung“ kennen.
Wann: Dienstag, 19. November 2019 von 9.00 bis 16.00 Uhr
Unsere Themen:
Erneuerbare Energien - praktisch erfahren
Einblick in die Nanowelt
Einführung in die Wasseranalytik
Küstenforschung: Salz der Meere
Die Experimentiertage spiegeln die Forschungsthemen vom Helmholtz-Zentrum Hereon wieder. Außerdem ermöglichen wir Ihnen bei Institutsbesichtigungen in direkten Kontakt mit unseren Wissenschaftlern und ihrer Forschung zu kommen.
Die Veranstaltungen sind kostenfrei und als Fortbildung für Lehrkräfte aus Schleswig-Holstein durch das IQSH und für Lehrkräfte aus Mecklenburg-Vorpommern durch das IQMV anerkannt. Sie erhalten eine entsprechende Teilnahmebestätigung.
Möchten Sie dabei sein? Oder kennen Sie interessierte Kolleginnen und Kollegen.
Anmeldung per Email unter: sabine.mendach@hereon.de
Ferienkurs 2019: Naturphänomenen auf der Spur
Vom 2. – 9. August sind 90 Schülerinnen und Schüler im Alter von sieben bis 14 Jahren in den Schulferien zum Experimentieren ins Schülerlabor Quantensprung gekommen.

Was verbirgt sich hinter dem Lotus-Effekt? Die Blätter der Kapuzinerkresse haben eine erstaunliche, selbstreinigende Eigenschaft. [Fotos: Franziska Grohn]
Im Rahmen der Ferienangebote der Jugendringe Lauenburg, Wentorf, Geesthacht und Schwarzenbek konnten sechs Gruppen von circa 15 Jugendlichen einen ganzen Vormittag lang im Schülerlabor Quantensprung den Naturphänomenen auf die Spur gehen.
Hat Wasser eine Haut? Wie kann sich eine Lotus Pflanze selbst reinigen! Ist ein Stärke-Wasser-Gemisch fest oder flüssig? Luft ist unsichtbar und stark; Wie kann das sein? Kann CO2 eine „Rakete“ in die Luft treiben? Diese Fragen und weiteres mehr standen im diesjährigen Ferienprogramm auf dem Plan.
Da viele Schülerinnen und Schüler im Rahmen des Ferienkurses schon mehrfach im Schülerlabor zu Besuch waren, legt sich das Quantensprung-Team mächtig ins Zeug, um jedes Jahr neue Themen und Experimente anbieten zu können. Der große Andrang auf den Kurs und die Begeisterung der Kinder beweist ihren Erfolg.
Franziska Grohn (15 Jahre) hat in einer kleinen Bildergeschichte die Erlebnisse des Ferienkurses zusammengefasst.
"Wissenschaft trifft Theater"
Vom 15. bis 18. April 2019 haben 18 Mitarbeiterkinder im Alter von sieben bis zwölf Jahren vier Tage experimentiert, Bühnenbilder gestaltet und Theater geprobt. Ein straffes Programm für Betreuerinnen und Jungforscher.
![Die Forscherameise Frida unterstützte die Kinder bei ihrer experimentellen Arbeit im Schülerlabor Quantensprung. [Foto: Hereon/Gesa Seidel] Ferienkurs Frida, die Forscherameise.](/imperia/md/images/hzg/imperiamdimagesgksscampus_und_karriere/imperiamdimagesgksscampus_und_karrierequantensprung/fittosize__730_0_1ef42769845e54cf6224b2adff069e03_20190415_ferienkurs_quantensprung_gseidel_12.jpg)
Die Forscherameise Frida unterstützte die Kinder bei ihrer experimentellen Arbeit im Schülerlabor Quantensprung. [Foto: Hereon/Gesa Seidel]
Abschluss des Ferienkurses im Schülerlabor Quantensprung war am Donnerstagnachmittag, der 18. April die große Theateraufführung im gut gefüllten GITZ-Konferenzraum. Die Aufregung war bei den kleinen Schauspielern und Nachwuchswissenschaftlern groß. Doch alles lief glatt und das Publikum war begeistert. Mit der aufgeweckten und abenteuerlustigen Ameise Frida haben sie so allerlei gelernt. Denn in das Theaterstück eingebettet wurden zwölf Experimente vorgeführt und erklärt.
Unter dem Motto „Wissenschaft trifft Theater“ haben Sabine Mendach, Birte Cirotzki und Tana Mayrhofer vom Schülerlabor Quantensprung ein neues Konzept erarbeitet und hervorragend vorbereitet. „Für uns war es eine besondere Herausforderung in nur vier Tagen ein ganzes Theaterstück mit Kindern so unterschiedlichen Alters auf die Beine zu stellen“, sagt Sabine Mendach, Leiterin des Schülerlabors. Denn Kerngeschäft des Schülerlabors ist es eigentlich, Oberstufenschülern ab der 10. Klasse die vielfältigen Forschungsfelder unseres Zentrums näherzubringen.
Alle Kinder waren sich jedoch einig, dass der Ferienkurs richtig viel Spaß gemacht hat. Viele fanden vor allem das Experimentieren toll. Doch vielleicht fällt bei Hereon-Kindern der Apfel auch hier nicht weit vom Stamm.
Ferienkurs 2018: Alles rund um Wasser
Schülerreporterin Franziska Grohn (14 Jahre alt) berichtet vom Ferienkurs „Alles rund um Wasser“ im Schülerlabor Quantensprung (Juli 2018)

Mit genügend Kochsalz bringt man ein rohes Ei zum Schwimmen. Foto: Franziska Grohn
Am 13. Juli 2018 habe ich mit einer Gruppe neugieriger Kinder im Schülerlabor Quantensprung experimentiert. Von Wentorf aus wurden wir mit dem laboreigenen Bus zum Helmholtz-Zentrum Hereon gefahren. Dort hat uns unsere Kursleiterin Ümmü Öztürk, die wir auch „Batman“ nennen durften, empfangen. Angefangen haben wir mit einem kleinen Wettbewerb, in dem es darum ging, wie viel Salz man in 100ml Wasser lösen kann. Wir haben nicht schlecht gestaunt, als Ümmü uns erzählt hat, dass beim letzten großen Salzwassereinbruch 4 Gigatonnen Salz in die Ostsee kamen, das entspricht dem Gewicht von 4 Milliarden Elefanten.
Danach haben wir ein rohes Ei zum Schwimmen gebracht, denn wer schon einmal Eier gekocht hat, der weiß, dass diese im normalen Wasser nicht schwimmen. Einige Jungs aus dem Kurs haben Ümmüs Kenntnisse zum Periodensystem getestet und sind dabei auf das Edelgas Argon, welches keine chemischen Bindungen eingeht, gestoßen. Daraufhin hat sich ein Junge Argon genannt, da er lieber ohne Partner arbeiten wollte. Wir mussten jedes Mal lachen, als Ümmü ihn so genannt hat. Mit zwei weiteren, aber etwas kleineren Experimenten konnten wir viel zum Thema Dichte herausfinden und wie schwer oder leicht Wasser ist.
Ein weiterer lustiger Versuch war das Wasserstapeln. Ich dachte zuerst, dass wir das Wasser in Gefäße füllen und die dann aufeinanderstapeln, doch es hat ohne Trennwände geklappt. Das war meiner Meinung nach das beste Experiment, da Ümmü vorher das Wasser bunt gefärbt hat und die Reagenzgläser mit dem Wasser einfach nur wunderschön aussahen. Bevor unser Bus uns wieder zurückgebracht hat, haben wir noch unser eigenes Plankton gebastelt und in einem Wettbewerb getestet, welches am langsamsten sinkt. Als Plankton werden alle Lebewesen bezeichnet, die passiv mit der Strömung schwimmen. Ich konnte mir, als ich morgens in den Bus gestiegen bin, nicht annähernd vorstellen, dass man in einem Schülerlabor in den Ferien so viel Spaß haben kann.

Die Teilnehmer*innen der Lehrerfortbildung im Mai 2018. Foto: Hereon/Birte Cirotzki
Das Team des Schülerlabors Quantensprung veranstaltete am 2. Mai 2018 von 9:00 bis 16:00 Uhr eine Fortbildung für angehende Physik-Lehrkräfte aus Schleswig-Holstein. Vermittelt durch das IQSH (Institut für Qualitätsentwicklung an Schulen Schleswig-Holstein) nahmen 17 Lehramtsanwärter die Gelegenheit wahr, unter dem Motto "Außerschulischer Lernort – Lernen an einem anderem Ort" einmal selbst im Schülerlabor zu forschen.
Durch eigenes Ausprobieren und Experimentieren lernten die Lehrkräfte die vielfältigen Angebote des Hereon-Schülerlabors kennen und erfuhren, wie Sie die Themen in ihre Lehrpläne einbauen können. Die Besichtigungen der jeweiligen Forschungsbereiche wie der Wasserstofftechnologie, Lasertechnik und Küstenforschung zeigte den Lehrkräften auch, dass die Themen des Schülerlabors auch die aktuelle Forschung am Hereon wiederspiegelt. Zum Abschluss des umfangreichen Tages besuchte die Gruppe die Mobilen Kuppel der Küstenforschung.
Organisiert wurde die Fortbildung von den Mitarbeiterinnen des Schülerlabors. Die Fortbildungen für Lehrkräfte werden mehrmals pro Jahr angeboten.
Sollten Sie und Ihre Kollegen Interesse an solch einer Fortbildung haben, dann melden Sie sich bitte bei
Dr. Sabine Mendach
Zwei Schülerinnen (13 und 15 Jahre alt) haben das Schülerlabor "Quantensprung" einige Tage lang mit einer Kamera begleitet. Dabei ist dieser tolle Film entstanden. In den Hauptrollen zu sehen: "Wasserstoff-Auto, Memorymetall-Büroklammer und Ferrofluid Bärlappsporen".
Viel Spaß beim Anschauen!

Foto: Hereon/Jan-Rasmus Lippels
Das Schülerlabor Quantensprung hat sein 15-Jähriges Jubiläum – und das wollen wir mit Ihnen feiern! Wir laden herzlich zu unserer Lehrerfortbildung ein:
Dienstag, 14. November 2017 von 9.00 bis 16.00 Uhr
Sie haben die Möglichkeit, ausgesuchte Forschungsbereiche (Institut für Küstenforschung, Institut für Werkstoffforschung) in unserem Helmholtz-Zentrum Hereon zu besichtigen und das Angebotsspektrum des Schülerlabors Quantensprung kennenzulernen. Experimentieren Sie mit uns in unseren modernen Räumlichkeiten!
Die Veranstaltungen sind kostenfrei und als Fortbildung für Lehrer in Schleswig-Holstein und in Mecklenburg-Vorpommern durch das IQSH bzw. durch das IQMV anerkannt. Sie erhalten eine entsprechende Teilnahmebestätigung.
Programm
Vormittag: Vorstellung und Ausprobieren der Experimentiertage:
- „Erneuerbare Energien praktisch erfahren“
- „Einblick in die Wasseranalytik“
- „Nanotechnologie“
- „Salz der Meere“
Mittag: Mittagessen in der Kantine des Helmholtz-Zentrums Hereon
Nachmittag: Besichtigung ausgesuchter Forschungsinstitute
Möchten Sie dabei sein? Oder kennen Sie interessierte Kolleginnen und Kollegen? Dann melden Sie sich gerne an!
Anmeldung bitte per E-Mail an Sabine Mendach (Laborleitung).
Bei Fragen wenden Sie sich gerne ebenfalls an mich.
Wir freuen uns auf zahlreiche Rückmeldungen,
Sabine Mendach & das Quantensprung-Team

Auf Helgoland haben im August drei Helmholtz-Zentren gemeinsamen den Ozeanworkshop „mehrmeer! 2017“ veranstaltet. Das Hereon, das Alfred-Wegner-Institut und das GEOMAR Kiel haben den Workshop gemeinsam ausgerichtet, gefördert wurde er vom Bundesministerium für Forschung und Bildung.
Zwanzig Teilnehmerinnen und Teilnehmer wurden aus insgesamt 80 Bewerbern bundesweit ausgewählt. Das Programm umfasste biologische, chemische und physikalische Fragestellungen der Meeres- und Klimaforschung sowie der Nutzung des Meeres und des Meeresschutzes. Die Themen reichten von unterschiedlichem Nährstoffangebot im Ozean über Aspekte der Biodiversität bis hin zum Plastikmüll im Meer. Höhepunkt des Programms war die zweitägige Ausfahrt auf dem Forschungsschiff „Heincke“.

Foto: Hereon
In den ersten beiden Ferienwochen konnten Kinder im Alter von 7 bis 14 Jahren einen Tag lang Experimente im Schülerlabor durchführen. So konnten sie zum einen selbst forschen, aber auch etwas über die Arbeit am Hereon lernen. Die Kurse fanden im Rahmen eines Ferienprogramms statt.
Diesen Sommer nahmen fünf Verbände umliegender Ortschaften das Angebot wahr. Knapp 100 Teilnehmerinnen und Teilnehmer experimentierten an sieben Tagen rund um das Thema Strom. Die Jungforscher lernten unterschiedliche Energiewandler kennen und konnten diese auch ausprobieren. Sie testeten, welche Materialien Strom leiten und welche isolieren. Stromkreise wurden gebaut, Schaltskizzen erstellt und zum Schluss konnte jedes Kind die Spannung einer Kartoffel hören.

Foto: Hereon
„Ich komme nächstes Jahr ganz bestimmt wieder!“, versprachen viele Kinder beim Einsteigen in den Bus nach Hause. Die Rückmeldungen der Kinder und Gruppenleiter waren durchweg positiv. Erfreulich ist auch, dass Kinder immer wieder nachfragten, was sie tun müssen, um Wissenschaftler zu werden.
Im Anschluss an das Ferienprogramm geht das Schülerlabor übrigens auf Kreuzfahrt. Dafür wurden bereits Kisten gepackt, Konzepte geschrieben und Anleitungen vorbereitet. Auf der „Mein Schiff 4“ von TUI Cruises bietet das Schülerlabor vom 07.08.-21.08. fünf Workshops für die Kinder auf der Kreuzfahrt an. Ab dem 28. August finden wieder wie gewohnt Schülerkurse und Lehrerworkshops statt.

Wasser stapeln, Plankton schweben lassen und Strom aus Kartoffeln erzeugen – zum 15-jährigen Jubiläum veranstaltete das Schülerlabor Quantensprung zwei Jubiläums-Jungforscher-Tage für Kinder von Hereon-Mitarbeiterinnen und Mitarbeitern.
In 15 Jahren Schülerlabor kann so einiges passieren: Sabine Mendach berichtet von 51.500 Schülerinnen und Schülern sowie 3.750 Lehrerinnen und Lehrern, die insgesamt über 2.530 Kurse im Quantensprung besucht haben.
Wie alles begann
Als das Quantensprung im Jahr 2002 gegründet wurde, war es eines der ersten Schülerlabore in der Helmholtz-Gemeinschaft. Initiiert wurde es von Prof. Günter von Sengbusch, dem ehemaligen Geschäftsführer des damaligen GKSS. Begonnen hat alles mit einem Labor, in dem Experimente zur Brennstoffzelle durchgeführt wurden. Das Schülerlabor wurde extra so gebaut, dass es nicht an ein Klassenzimmer erinnert. Schüler sollten hier einen Tag lang das Gefühl haben, in einem „richtigen“ Forschungslabor zu arbeiten. Auch war das Labor komplett mit Laptops ausgestattet, was zu der Zeit noch eine Besonderheit war. In den ganzen Jahren wurde nur ein einziges Mal die Werbetrommel für das Schülerlabor gerührt: Zur Eröffnung wurden 400 Schulen eingeladen. Seit dem ist das Labor fast jeden Tag belegt.

Bei den Jubiläums-Jungforscher-Tagen konnten die Kinder „Alles rund um's Wasser" untersuchen. Foto: Hereon/Gesa Seidel
In den ersten Jahren waren „Wasseranalytik“ und „Erneuerbare Energien“ (Wasserstoff und Brennstoffzelle) die beiden Hauptthemen. Mittlerweile gibt es auch das Thema „Salz der Meere“ aus dem Bereich der Küstenforschung, welches von der abgeordneten Lehrerin Birte Cirotzki mit Unterstützung von Wissenschaftlern aus dem Institut für Küstenforschung konzipiert und bisher mehrmals erfolgreich durchgeführt wurde. Im September 2016 wurde das Spektrum auf „Einblicke in die Nanotechnologie“ erweitert. „Die Nanowelt ist so spannend und vielfältig, da mussten wir so ein Thema auch im Schülerlabor anbieten“, meint Natalya Grohn, Mitarbeiterin im Quantensprung. Sie hat das Thema federführend im Schülerlabor etabliert.

Am zweiten Tag war „Alles rund um Strom" das Tagethema. Foto: Hereon/Gesa Seidel
„Wir wollen den Kindern zeigen, dass Wissenschaft dynamisch ist. In der Schule denken viele noch, es gäbe nur eine richtige Antwort und das alles schon erforscht wäre“, sagt Ümmü Gülsüm Öztürk, Mitarbeiterin im Schülerlabor. Sabine Mendach, Leiterin des Labors, ergänzt: „Mit unseren Experimenten wollen wir den Forschergeist wecken und zeigen, dass man manchmal sogar nur mit Modellen an die Wirklichkeit herankommen kann.“ Die Experimente verändern sich im Lauf der Zeit – genauso wie die Forschung. Wurden früher noch mit Methanol-Brennstoffzellen gearbeitet, so wird heute im Schülerlabor – ebenso wie im Institut für Werkstoffforschung – Metallhydridspeicher für die Brennstoffzellen genutzt.



































